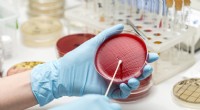
Trin-for-trin guide til at identificere ukendte bakterier i laboratoriet

Mens de fleste mennesker betragter blodtype som kun relevant for transfusioner, viser forskning, at det også kan signalere modtagelighed for visse sygdomme.
En undersøgelse fra 2019 i BMC Cancer analyserede 4.932 mavekræftpatienter og 6.158 kontroller for at undersøge ABO-blodgrupper og kræftrisiko. Forfatterne fandt, at personer med type A-blod havde en 13 % højere risiko for mavekræft sammenlignet med type O, og type AB havde en 18 % højere risiko. En metaanalyse af relaterede undersøgelser bekræftede lignende mønstre:en 19 % øget risiko for type A og en 9 % stigning for type AB.
Forfatterne bemærkede også, at type A-blod er forbundet med højere modtagelighed for Helicobacter pylori , den primære årsag til mavekræft. Det er vigtigt, at undersøgelsen viste, at risikoen forblev forhøjet for type A, selv i fravær af en H.pylori-infektion, mens risikoen for type AB kun steg, når infektionen var til stede.
At have blodtype A eller AB garanterer ikke, at du vil udvikle mavekræft. Genetik er kun en brik i puslespillet. Alder, køn, etnicitet, rygning, alkohol, diæter med højt saltindhold og endda miljøændringer påvirker også risikoen.
Mavekræft er fortsat den femte hyppigste kræftsygdom på verdensplan og den tredje hyppigste årsag til kræftdød. American Cancer Society forventer 30.300 nye tilfælde i USA og 10.780 dødsfald i 2025. Heldigvis er en BMC Public Health fra 2024 undersøgelse rapporterer et fald i forekomst og dødelighed i løbet af det seneste årti i mange regioner, selvom befolkningsvækst kan opveje disse gevinster.
At kende din blodtype kan hjælpe dig med at deltage i informerede samtaler med din sundhedsplejerske og træffe forebyggende foranstaltninger - regelmæssige screeninger, afbalanceret ernæring og undgå tobak og overskydende alkohol.
Varme artikler